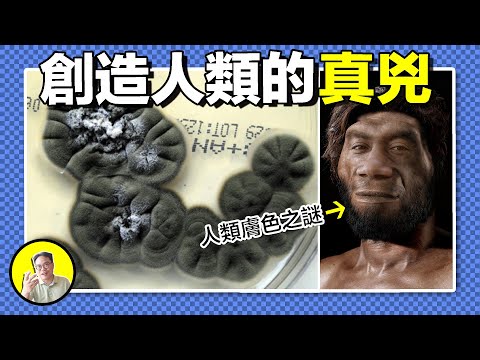
切爾諾貝利污染區發現大量變異生物，核輻射下誕生的黑色生命，竟然是人類殖民星際的希望......｜總裁聊聊

About 112 results for "UC2j5Kw9qDWCZmU_emgqeguA"
Featured Results

PT18M30S
巨石遺跡來自史前星團,金字塔曾有神明居住?德國記者發掘真相,卻死於非命。最忠實的仆人一直在安第斯山脈深處守護著阿卡科爾,最後的避難所......|總裁聊聊
總裁聊聊Mar 21, 2025
PT16M38S
梵淨山:釋迦彌勒殿下,藏著吃人的九龍池!村民為何一去不返?禁地怪獸真身竟與哀牢山有關?百萬年地轉星移,山頂佛影中藏著大乘佛教的真諦......|總裁聊聊
總裁聊聊Feb 18, 2025
神秘的數學公式,2000多年前的蒸汽機,預言機,飛行器,希臘的神秘知識到底從何而來,牛頓的知識真的來自消失的亞歷山大圖書館麼,今天我們就來聊聊希臘英雄的秘密......|總裁聊聊
總裁聊聊Feb 15, 2025
1914年,沙克爾頓的南極探險隊中多了一個不存在的人,所有人都知道,卻無人敢提起祂。也是祂在指引玄奘和成吉思汗嗎?無數人見到过,這不可言說的存在究竟是什麼......|總裁聊聊
總裁聊聊Jan 23, 2025Swipe to view more pages